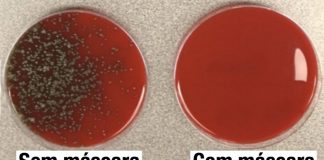
Cientista demonstra o efeito de usar uma máscara e o que acontece quando não se usa Cientista demonstra o efeito de usar uma máscara e o que acontece quando não se usa

Por que os homens nunca conseguem encontrar as coisas?
Quem vive em uma casa com um homem com certeza vai concordar com essa afirmação: os homens nunca conseguem encontrar nada. E sempre acabam...
Você sabe o que é hipergamia feminina? 7 lições para entender...
A biologia tem muito a responder, e a hipergamia feminina é um aspecto disso. Aprenda como as mulheres procuram “biologicamente” o parceiro ideal.
Parece que...
Coisas que só poderiam acontecer em uma segunda-feira de manhã
Acredito que todos nós concordamos, a manhã de segunda-feira sempre é um momento crítico para qualquer ser humano.
Além de acordar cedo e ter...
Mulher tailandesa usa açafrão para tratar infecção em seu gato e...
Você já imaginou existir um gato Pikachu de verdade? Recomendamos que vocês não tenter fazer isso em casa com seus animais de estimação sem...
Cenas por trás dos bastidores de filmes mostram o outro lado...
O cinema e toda sua super produção são verdadeiramente fantásticas! São produzidos os mais incríveis cenários e criaturas do mundo mágico que se transformam...
Irmãs albinas surpreendem o mundo com sua beleza extraordinária
Essas duas lindas meninas do Cazaquistão desafiaram estastísticas mundiais. Isso porque Asel e Kamila Kalaganova, que possuem 12 anos de diferença, nasceram na mesma...
Este cachorro está convencido de que é um gato e faz...
Este fofíssimo cachorro bicolor da raça pitbull de apenas 2 anos foi adotado pela família Castiller, e assim teve que compartilhar da sua nova...
Cientista demonstra o efeito de usar uma máscara e o que...
Mesmo com as recomendações da Organização Mundial de Saúde do uso de máscaras, muitas pessoas ainda permanecem resistentes ao uso ou a utilizam de...
Homens que se casam com mulheres inteligentes vivem mais
Pense em sua mulher ideal: o cérebro dela está no topo da sua lista quando você menciona suas melhores qualidades? Talvez devesse estar.
Pesquisas sugerem...